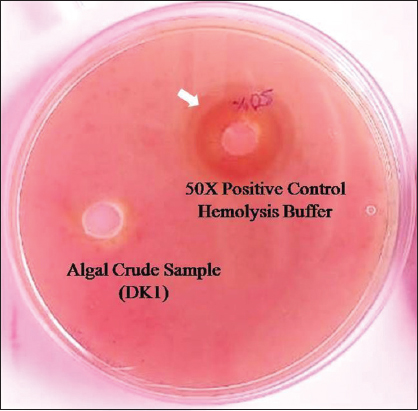

1. INTRODUCTION
The world population growth rate is increasing by leaps and bounds. In 2017, the United Nations of Organization projected that, in 2050, there would be 9.8 billion people on the planet and 11.2 billion by the year 2100. The existing supply of protein would fall short of meeting the need for protein in the future. Moreover, people are becoming aware of how nutrition and health are related. Now, everyone must make sure they have access to alternative food sources. The other food sources must satisfy the biological impacts and metabolic requirements. Customers’ demand for a healthy lifestyle consequently takes on greater significance. Thus, the functional food sector has experienced remarkable growth. Protein enriched algal biomass may be used as a raw material in that sector. The dried biomass of microorganisms (including algae) is known as single-cell protein (SCP). SCP may be an alternate and possible render of protein supplement compared to conventional protein resources in food. According to the protein sources, SCP can be categorized into fungal protein, bacterial protein, yeast protein, and algal protein. Among all those protein sources, algal SCP is the best source of protein because algae contain 4–6% of total nucleic acid per unit dry algal biomass having higher protein content [1]. Microbial biomass with higher nucleic acid, that is, DNA and RNA contents, limits its usage as protein supplements in society. Higher nucleic acid intake by the human body creates many health hazards [2].
Algal biomass has become a point of attraction for different value-added products generation. Algae are a strong contender as a protein source. Algal photoautotrophic growth lacks of need for irrigation or arable land, climatic independence, and high protein content compared to conventional agriculture using protein-rich crops. The most important components in algae are protein, amino acids, carbohydrates, lipids, vitamins (e.g., A, B1, B2, B6, B12, C, E, nicotinate, biotin, folic acid, and pantothenic acid), and minerals (e.g., Na, K, Ca, Mg, Fe, and Zn) [3,4]. Aforementioned biocomponents of algae have a positive impact on human health. Algal biomass produces food, feed, fuel, vitamin, and nutraceuticals [4-6]. Algal-derived polyphenols and polysaccharides have well-known for their biological functions [7]. Arthrospira platensis, Chlorella vulgaris, and Aphanizomenon sp. are good sources of protein and nutraceuticals, having 65–75% (w/w) of protein [8]. Spirulina platensis is a good source of protein and amino acids that help people to fight against diabetes, hypertension, and high blood pressure, as well as lose weight [9], and also act as an immune enhancer. Another important biomolecule in algal biomass is chlorophyll which has a good impact on human health. Several scientific researchers have claimed that chlorophyll could reduce the probability of cancer, and it binds with carcinogenic chemicals, which are known as aflatoxin and prevent liver, stomach, colon, and skin cancer [10,11]. Algae subject to self-shaded or riparian canopy conditions synthesize larger chlorophyll relative to algal biomass than those exposed to high light intensity [12].
In the present study, algal isolates were gathered for our research investigation from the natural water body, the Kangsabati River. The cause of the selection of the river Kangsabati and its different sampling sites is to know the effect of the topographical variation and community habitat brought any impact on algal biomass and biomolecule generation. Kangsabati River basin is primarily inside the Indian state of West Bengal and is roughly defined by the 86° 37′ 55.30″ E – 86° 47′ 23.35″ E longitudes and the 22°55′ 16.53″ N- 23° 2′ 30.41″ N. Our novel algal isolates (DK1) have been identified at Mohanpur, which is in the district of Paschim Medinipur, and their latitude and longitude are 21.8398°N and 87.4232°E, respectively. Water temperature lays range between 25°C and 28°C in the summer months and 20–22°C in winter months; water pH lies 7 during the months of isolate collection. Epiphytic algal isolates were taken from the photic (euphotic) zone of the river Kangsabati in the winter season. The main objectives of this study are to attain the successful screening and the isolation of novel algal isolates from the various locations along the river Kangsabati (K-ecosystem) to obtain the highest possible yield of biomass, along with the highest percentage of protein, chlorophyll with the least amount of nucleic acids. In addition, it is crucial to demonstrate the biomass’s safety, particularly when cyanotoxins are thought of as SCPs for dietary supplements using hemolysin assay.
2. MATERIALS AND METHODS
2.1. Sample Collection
The river Kangsabati’s six separate places provided six different microalgal isolates, namely, Mohanpur (DK1), Temohoni (DK2), Daspur (DK3), Binpur (DK4), Dherua (DK5), and Chalkdaulat (DK6) in the district of Jhargram and Paschim Medinipur, West Bengal [Figure 1] during December 2019 to February 2020 at the winter seasons (when water temperature belong 22°C–25°C and pH-7) as it is the favorable season for algal growth. The various types of algal samples are found in the Indian state of West Bengal using latitude and longitude, such as DK1 is situated at 21.8398°N, 87.4232°E; DK2 is situated at 22.4853°N, 87.5618°E; DK3 is situated at 22.6068°N, 87.7246°E; DK4 is situated at 22.5830°N, 86.9186°E; DK5 is situated at 22.4888°N, 87.0968°E; and DK6 is situated at 22.4288°N, 87.4715°E. The collected algal isolates were cultured in the laboratory of JIS University, Biotechnology Department, Agarpara, Kolkata, West Bengal for characterization and analysis of biomolecules. In this study DK6, isolate declined growth every time at room temperature (~22oC). To this end, the DK6 sample did not consider for further study.
 | Figure 1: Sampling sites of the river Kangsabati. [Click here to view] |
2.2. Screening and Isolation
Algal isolates were individually inoculated in sterilized 50 mL falcon tubes with 25 mL of sterilized Bold’s basal medium (BBM) in the laboratory after filtering and serial dilution (10-8 times). To prepare 200 mL BBM, the following key nutrients were required: 5g.-NaNO3, 1.5g.-MgSO4.7H2O, 1.5g.-K2HPO4, 3.5g.-KH2PO4, 0.5g.-CaCl2.2H2O, 0.5g.-NaCl, 10g.-EDTA, 6.2g.-KOH, 0.996g-FeSO4.7H2O, 2.28g.-H3BO3,1.7g.-ZnSO4, 0.142g-MoO3, 0.098g.-Co(NO3)2.6H2O, 0.288g.-MnCl2, and 0.314g.-CuSO4.5H2O [13,14]. To maintain the purity of the microalgae cultures, repeated streaking on an agar plate was done routinely. Isolated algal samples were cultured for 18 days at 22(±2)°C within 24 h using fluorescent lights. During the exponential growth phase, microalgal cultures were taken and homogenized by centrifugation at a speed of 13,000 rpm for 15 min. The pellet part of the algal samples was stored at −20°C (in 15% v/v glycerol) for further experiment.
2.3. Preparation of Comparative Standard Curve between Algal Dry Biomass and Optical Density (OD) of Algal Culture
Algal isolates were grown in a 250 mL conical flask containing 100 mL BBM broth under batch cultivation to prepare the standard curve of OD versus biomass. Inoculum volume (5 mL) of each isolate was inoculated into each labeled flask separately. Daily 12/12(L/D) photoperiod batch culture was conducted, with temperature maintained at 22(±2)°C on a shaker at 120 rpm. After that, a standard curve of OD versus dry weight was created when culture OD750 was more than 1 at a given point in the development cycle of algae. In the experiment, before taking the algal isolates, each empty 2 mL Eppendorf was measured and noted down. Each isolate was divided into two sets of 2 mL Eppendorf tubes and centrifuged at 12,000 rpm for 10 min. The volumes used for each isolate were 400, 800, 1200, and 1600 μL. The pelleted Eppendorf was then maintained in a dryer at 40°C for drying after the supernatant was removed. After drying the pellet, each Eppendorf was measured again to get the weight of the biomass. The Eppendorf was then vortexed to dilute the dry algal biomass with 1 mL of distilled water, resulting in a final volume of 2 mL. Then, the measurement of the absorbance of the isolates was done with a spectrophotometer at 750 nm wavelength [15]. These standard straight-line equations help to measure the amount of biomass from spectrophotometric value [Supplementary Figure 1].
2.4. Growth Curve Study of Algal Isolates
Daily 12/12(L/D) photoperiods were used to study the batch cultivation, and the temperature was kept at 22(±2)°C on a shaker for 18 days at 120 rpm. Measurements of concentrations of algal isolates were determined at 3 days intervals by UV-Vis spectrophotometer (using UV-Vis spectrophotometer from Shimadzu, Model No: UV-1800) at 750 nm. After that, we determined the amount in (mg/mL) of algal growth using OD versus biomass standard equation [15].
3. PROTEIN QUANTIFICATION OF ALGAL ISOLATES
3.1. Protein Extraction from Algal Isolates
We followed the protocol of Slocombe et al. [16] for the extraction of protein from algal isolates. 1 mL of the batch culture’s algal sample was obtained on the day “0”, maintained in each labeled Eppendorf tube, and centrifuged at 12,000 rpm for 10 min. The pellet containing the Eppendorf was then stored in an incubator for 30 min for freeze-drying after the supernatant had been removed. After that, 0.2 mL 24% (w/v) TCA (Trichloroacetic acid) was added to each lyophilized microalgal isolates biomass containing Eppendorf, and it was vortex to dissolve the biomass completely. Now, it was incubated at 95°C for 15 min. It was cooled to room temperature after incubation. It was then centrifuged with 0.6 mL of distilled water for 20 min at 4°C at 15,000 rpm. The pelleted portion was re-suspended in 0.5 mL of 0.1 N NaOH and maintained at 55°C for 3 h after discarding the supernatant portion. Then, centrifugation for 20 min at 15,000 rpm was followed at room temperature [16]. The Bradford test for protein estimation was performed on the retained supernatants.
3.2. Protein Estimation
For protein estimation, 250 μL supernatant was kept in an Eppendorf. Then, 750 μL PBS buffer (pH - 7.4) and 1000 μL Bradford reagents were mixed into that supernatant. The buffer solution used in our study, phosphate-buffered saline (PBS), had a pH of 7.4. It was a salt solution based on water that contains potassium dihydrogen phosphate, sodium chloride, potassium chloride, and disodium hydrogen phosphate. The buffer had aided in keeping the pH steady. PBS, a non-toxic solution, was commonly used in biological laboratories. PBS had improved protein stability and, in contrast to water, prevents osmosis from rupturing or shriveling up cells. In addition, it had preserved the protein’s integrity. Otherwise, it was unfolded, denatured, damaged, or entangled with DNA and lipids, which were irrelevant cell components. Bovine serum albumin (BSA) was used to prepare the standard protein curve. A known concentration of BSA was standardized using the Bradford method [17], and a standard protein curve [Supplementary Figure 2a] was prepared at the earliest. To prepare the Bradford reagent, at first, 100 mg of Coomassie Brilliant Blue G-250 was dissolved in 50 mL of 95% ethanol. 100 cc of phosphoric acid at 85% (w/v) was added to this solution. A final volume of 1 L was achieved by diluting the obtained solution. Coomassie Brilliant Blue G-250, 4.7% (w/v) ethanol, and 8.5% (w/v) phosphoric acid were the final proportions in the reagent [17]. Afterward, the unknown protein concentration was compared to the known concentration of the protein standard curve in μg/mg unit. OD value was taken at 595 nm wavelength of light absorbance using a spectrophotometer. This procedure was followed for 0, 3rd, 6th, 9th, 12th, 15th, and 18th days of algal culture.
4. EXTRACTION AND ESTIMATION OF TOTAL CHLOROPHYLL (a and b) PIGMENTS
Total chlorophyll measurement had played important role during algae based SCP production as predominant indicator of photosynthesis and biomass generation under broad spectrum of light source and intensity. Moreover, total chlorophyll content in algal SCP had also been enumerated in this present study because it had always considered as essential precursor for biogenesis of diverse ranges of vitamins, antioxidants, and nutraceutical constituents [18,19]. In this present study, on day 12th, 1 mL of the algal isolate from the batch cultivation was placed into each separated, labeled Eppendorf tubes, and centrifuged for 10 min at 12,000 rpm. The supernatant had been discarded. The pelleted part was kept in a dryer at 50°C for drying. Then, 1 mL 90% (v/v) acetone was poured into it as a solvent, and it was sonicated repeatedly until or unless the residue became colorless [18]. After two consecutive sonications, an ice bath treatment was given. Finally, it was centrifuged again at 8000 rpm for 8 min. To measure the absorbance of these samples with a spectrophotometer at 645 nm and 663 nm, wavelength (against the solvent blank), 1 mL of isolate extract, and 1 mL of distilled water were poured into a 2 mL cuvette [20]. A calibration curve was prepared to relate the absorbance with the day. This procedure was followed for the 12th day of the algal growth culture. 2 mL of solvent (Acetone) was filled in a 2 mL cuvette and used as a blank. Using equation 1, the total chlorophyll “a” and “b” was calculated at [21,22].
 |
5. QUANTIFICATION OF TOTAL NUCLEIC ACID (DNA AND RNA)
5.1. DNA Extraction
The DNA extraction protocol had been provided by the DNAzol (Thermo Fisher Scientific) manufacturers and was used to quantify the cellular DNA, a patent-pending DNA isolation reagent containing guanidine thiocyanate and a detergent mixture. It is a purely non-toxic and ready-to-use reagent for the isolation of genomic DNA from microalgal biomass [23]. On the 12th day, 1 mL of the algal isolate was taken into each separately labeled Eppendorf from the batch culture and centrifuged at 12,000 rpm for 10 min. After that, the supernatant was discarded. The pellet containing Eppendorf was kept in an incubator for 30 min. After drying the pellet, 1 mL of DNAzol reagent was added to the dry pellet and sonicated 5 times; between two consecutive sonications, Eppendorf was kept in an ice bath.
5.2. DNA Estimation
For the estimation of DNA, we followed the procedure of the diphenylamine (DPA) method [24]. A spectrophotometer (UV-Vis spectrophotometer from Shimadzu, Model No: UV-1800) was used to measure the standard samples’ OD at 595 nm. The only minor change in our experiment was that for a reaction volume of 2 mL, the reaction time was 10 min in a boiling water (100°C) bath rather than 1 h at 60°C for a reaction volume of 1.5 mL. We obtained the most accurate findings when DNA was combined with impurities. Finally, from the sonicated isolates, 250 μL was kept in another Eppendorf, along with 750 μL of Tris-buffer and 1000 μL of diphenylamine reagent were mixed into it to make the final volume of 2 mL. After that, it was kept in a boiling water bath for 10 min. As a result, a color change was observed, and finally, O.D was taken at 595 nm against an Eppendorf containing 250 μL DNAzol, 750 μL Tris buffer, and 1000 μL DPA used as a blank. A calibration curve was prepared to relate the absorbance with the day. This procedure was followed for the 12th day of the algal growth culture. All these data were compared with a standard curve of DNA to calculate the concentration of DNA in μg/mg unit. The known concentration of DNA was standardized using the DPA method [Supplementary Figure 2b]. From here, the unknown concentration of DNA was compared to know the DNA concentration in μg/mg unit.
5.3. RNA Extraction
From the batch cultivation of algae, on the day 12th, 1 mL of algal isolates was taken into each separately labeled Eppendorf tubes and centrifuged for 10 min at 12,000 rpm. After that, the supernatant was discarded, and the pellet containing Eppendorf was kept in an incubator for 30 min. The extraction protocol had been provided by Trizol (Thermo Fisher Scientific) a manufacturer used to quantify the cellular RNA. It is based on the phenol-chloroform extraction procedure [25]. After adding 1 mL of Trizol reagent to the dried pellet, it was sonicated 5 times. Eppendorf tube was placed in a cold bath in between each sonication.
5.4. RNA Estimation
For the estimation of RNA, we followed the procedure of the standard orcinol reagent method [26]. The only minor change in our experiment was that we used citrate buffer (pH-6), which inhibited base hydrolysis during the period of RNA estimation, and there actual volume was 2 mL; the reaction time was 30 min in a boiling water (100°C) bath. We obtained the most accurate findings when RNA was combined with impurities. The OD at 665 nm of the standard samples was then determined using a spectrophotometer (UV-Vis spectrophotometer from Shimadzu, Model No: UV-1800). After sonication, 250 μL of the sonicated algal isolates was kept in another Eppendorf. Then, 750 μL of citrate buffer and 1000 μL of orcinol reagent were mixed within it, and the final volume was 2 mL. After that, it was kept in a boiling water bath for 30 min. There was a color change, and finally, the OD value was taken at 665 nm wavelength of light absorbance against an Eppendorf tube containing 250 μL Trizol, 750 μL citrate buffer, and 1000 μL orcinol reagent, used as a blank. A calibration curve was prepared to relate the absorbance with the day. This procedure was followed for the 12th day of the algal growth culture. All these data were compared with the standard curve of RNA to calculate the concentration of RNA on the same amount of biomass. A known concentration of RNA was standardized using the Orcinol method, and a standard RNA curve was prepared at the earliest [Supplementary Figure 2c]. From here, the unknown concentration of RNA was compared to the known concentration of RNA in μg/mg unit dry algal biomass.
6. PATHOGENICITY TEST
The separated algal isolates were centrifuged at 10,000 rpm for 5 min. Following removing the supernatant, the PBS buffer was added to the algal pellet. Then isolated algal cultures were sonicated for 5 min to break them down. After that, this undeveloped culture was inoculated into sheep blood agar. As a positive check, a 50X blood cell lysis buffer was employed [27,28].
7. MORPHOLOGICAL ANALYSIS
Morphological analysis is important to identify microalgae. It has become a useful tool to identify the algae considering their high-resolution photomicrographs [29]. The compound bright field microscope was used to study the morphological characteristics of the algal isolates. From the pure culture, one drop of each algal isolate was spread over three different clean grease-free slides. Algal isolates were found after drying with low and high magnification. For light microscopic analysis ×400, ×1000 magnification in Magnus MLXiPlus, Magcam DC3 was used. All isolates had prominent green chlorophyll, meaning all collected algal isolates belonged to the class Chlorophyceae [30]. The binomial name of the microalgae was not mentioned here because only morphological description is insufficient to identify an alga taxonomically. For example, the Chlorella-clade is distinguished by its members’ great cryptic variety; yet, none of the morphological traits individually assessed was adequate to conclusively establish the taxonomic position of the clade’s members. Some morphological characteristics were varied, frequently altered by technical manipulations during sample preparation for the monitoring of water bodies, or they were lost altogether. Eight groups in the Chlorella-clade were described using a combination of morphological, biochemical, ultra structural, molecular genetics, physiological, and ecological data (a polyphasic approach). Assumptions were made regarding the division of the genera and species within these groups [31]. Hence, we did not mention the binomial name of the isolated alga and it was sent for DNA sequencing for taxonomic identification.
8. RESULTS AND DISCUSSION
All those limitations related to our research design mentioned at the earliest had been overcome by our trial and error methods. Initially, we had selected springtime for sampling, but we failed to grow the algal isolates. That is why we had chosen the winter season and we got success. Another one was the selection of cultured medium. We had given priority to both the BBM broth and BG-11 broth. In BBM broth, we found the growth of algal isolates but in BG-11, no growth was observed. Finally, we selected the BBM broth. In the experiment, we got essential entities of microalgae isolates from the Kangsaboti river water in BBM agar media. Moreover, DK1, DK2, DK3, DK4, and DK5 algal isolates’ growth phases were studied in BBM broth medium to compare the growth rate under the same condition (room temperature, i.e., 22(±2)°C).
8.1. Growth Curve Determination
A growth curve analysis can determine the maximum growth time (days) for comparative tests and the amount of commercial development required for the highest possible biomass production. The calculation of biomass concentrations using OD at 750 nm as opposed to 680 nm was more accurate. Depending on the physiological stage of the organisms, photosynthetic pigments vary widely. A wavelength cutoff of 750 nm is used in microalgae cultures to prevent interferences with absorption caused by these pigments [15]. Inoculum development was carried out on BBM media. Algal isolates showed very fast and maximum growth on the 6th–12th days in the log period. All algal isolates attained the exponential phase on 12 days in BBM medium [Figure 2a]. Like cell division, it may be considered that the day 0–6 days is a preparatory phase where necessary cell organelles are synthesized for further multiplication onward. The maximum growth of algae isolates in BBM media showed on the 12th day. On day 12th, the maximum concentrated algal culture showed in DK1 (5.67 mg/mL), DK4 (5.84 mg/mL), and DK5 (4.24 mg/mL), but, in DK2 and DK3, it was 3.65 and 2.72 mg/mL, respectively, and it was lower than DK1, DK4, and DK5 [Figure 2b].
 | Figure 2: (a) Growth profiles (in terms of algal biomass produced) of collected algal isolates. (b) Comparative study of biomass concentration (mg/mL) in 12 day of algal isolates. [Click here to view] |
8.2. Protein Quantification
In BBM media, algal isolates showed maximum growth in the log period on the 6th–12th day. Spontaneously, five algal isolates attained the maximum protein concentration on 12 days in BBM medium [Figure 3]. Out of five algal isolates, DK1, DK4, and DK5 algal isolates were the best isolates in terms of protein yield on 12th-day biomass estimation. It was 2.057 mg/mL, 1.955 mg/mL, and 1.761 mg/mL of dry biomass, respectively, and low protein yield in DK2 and DK3 isolates and it was1.26 mg/mL and 0.936 mg/mL of dry biomass, respectively [Figure 4a]. If we expressed the protein content in μg/mg, the amount of protein content would be 362.52, 343.41, 345.11, 334.98, and 415.08 μg/mg of dry biomass of the five algal isolates, namely, DK1, DK2, DK3, DK4, and DK5, respectively, on the day 12th [Figure 4b]. This data (μg/mg) concludes that DK2 and DK4 had lower protein content in their dry biomass. DK2 isolates were not considered for further study after the slow growth rate. Only DK1, DK4, and DK5 were considered for further comparative analysis. Moreover, experimental results show that DK1 algal isolate (per dry biomass) contains 36(±2) % total protein content which is promising and comparable with existing algal regimes [Table 1]. However, DK1 algal isolate might accumulate an even higher quantity of total protein content per unit biomass if multi-process parameter optimization, stress responsive studies, and metabolic engineering can be done in the near future as a follow-up study toward large-scale production [32,33].
 | Figure 3: Protein concentration (mg/mL) curve of algal isolates. [Click here to view] |
 | Figure 4: (a) Comparative study of protein concentration (mg/mL) in 12 days of algal isolates; (b) comparative study of protein concentration (μg/mg) in 12 days of algal isolates; and (c) in protein estimation color change (yellow to blue). [Click here to view] |
Table 1: A comparative summarization of bimolecular contents in DK1 with other algae and mushroom (where ND refers to not-determined)
| Organisms | Protein percentage (dry weight basis) | Nucleic acid percentage (dry weight basis) | Total nucleic acid percentage (dry weight basis) | References | |
|---|---|---|---|---|---|
| DNA | RNA | ||||
| Mushroom | |||||
| Agaricus bisporus | 39.84 (±0.66) | 0.17 (±0.01) | 2.49 (±0.08) | 2.66 | [37,38] |
| Volvariella volvacea | 41.00(±3.79) | 0.29 (±0.01) | 3.59 (±0.20) | 3.88 | [37,40] |
| Pleurotus sajor-caju | 39.25 (±3.89) | 0.68 (± 0.11) | 4.39 (±0.46) | 5.07 | [40] |
| Algae | |||||
| Arthrospira platensis | 62.21 | 1.34 | 4.13 | 5.47 | [36] |
| Chlorella pyrenoidosa | 65.2 | ND | ND | ND | [41] |
| Aphanizomenon flosaquae | 62.4 | ND | ND | ND | [42] |
| DKI algal isolate | 36 (±2) | 0.129 (±0.08) | 0.392 (±0.19) | 0.52 (±0.13) | Present study |
8.3. Chlorophyll Quantification
Further studies were done for the selection of the best isolates out of three algal isolates namely DK1, DK4, and DK5 in terms of growth rate, protein, and chlorophyll content. The total chlorophyll estimation result showed the total amount of chlorophyll in DK1 isolate was 134.45 μg/mg on the day 12th. On the same day, in DK4 and DK5, it was 103.26 and 114.53 μg/mg, respectively. The comparative study showed that the highest chlorophyll concentration was observed in the DK1 algal isolate [Figure 5]. Thus, higher level of total chlorophyll content had shown a clear indication that DK1 could be very effective algae based SCP having higher antioxidant activity, vitamin content, and higher nutraceutical properties [18,19,22].
 | Figure 5: Comparative study of concentration (μg/mg) of chlorophyll and nucleic acid in best three isolates. [Click here to view] |
8.4. Total Nucleic Acid Quantification
On the day 12th, the total amount of DNA was quantified, and it was 1.29, 1.3, and 1.77 μg/mg of dry biomass of DK1, DK4, and DK5 algal isolates, respectively. However, the total amount of RNA of DK1, DK4, and DK5 isolates were 3.92, 3.26, and 5.54 μg/mg, respectively. DK1 and DK4algal isolates had less amount of nucleic acids (DNA+RNA), and it was 5.21 and 4.56 μg/mg of dry biomass on the day 12th of culture. However, in the DK5 isolate, the residual amount of nucleic acid was 7.31 μg/mg on the same day of biomass estimation which was higher than both DK1 and DK4 algal isolates [Figure 5]. On the contrary, DK1 isolates also had a high amount of protein, and chlorophyll and the residual amount of nucleic acid were low. In comparative Table 1, it had clearly been shown that DK1 algal isolate bears comparatively lower total nucleic acid percentage per unit dry algal biomass weight, that is, 0.52(±0.13)%. It was also a good sign as a food supplement with minimal side effects on human health [34].
8.5. Pathogenicity Determination for Potent Algal Isolate DK1
DK1 algal isolates’ crude culture did not show any zone in the agar plate. However, 50X buffer showed a clear zone on the sheep blood agar plate. This result showed that the DK1 algal isolates had no pathogenic activity compared to the blood cell lysis buffer [Figure 6]. This positive control lysis buffer broke down the red blood cell by disrupting the cell membrane. The non-pathogenic gesture of DK1 isolate could establish it as an enormously acceptable cheaper SCP supplement for under-nourished communities and large-scale production in food industries [22].
| Figure 6: Hemolysin assay in sheep blood agar medium of best sample (DK1). [Click here to view] |
8.6. Morphological Analysis of DK1Algal Isolate
Microphotographs of all the microalgae involved in this study are given in Figure 7. Figure 7a and b indicated Mohanpur (DK1) 400X, 1000X; Figure 7c and d indicated Temohoni (DK2) 400X, 1000X; Figure 7e and f indicated Daspur (DK3) 400X, 1000X; Figure 7g and h indicated Binpur (DK4) 400X, 1000X; and Figure 7i and j indicated Dherua (DK5) 400X, 1000X magnification of algal isolates. Only novel algal isolates (DK1) were observed in the laboratory with the help of a bright field microscope. Under the microscope, the following characteristics were observed: Isolates were unicellular with a thin cell wall, non-motile, that is, lack of flagella, spherical or ellipsoidal shape, cells were solitary and few cells formed clumps, chloroplast cup-shaped and were prominent but parietal in position and there was a vacuole inside the cell [35].
 | Figure 7: Microphotographs of all the microalgae involved in this study. (a and b) Mohanpur (DK1) ×400, ×1000; (c and d) Temohoni (DK2) ×400, ×1000; (e and f) Daspur (DK3) ×400, ×1000; (g and h) Binpur (DK4) ×400, ×1000; (i and j) Dherua (DK5) ×400, ×1000 magnification. [Click here to view] |
8.7. Comparative Overview on Biochemical profiles of DK1 Algal Isolate as Single-Cell Protein
A comparative overview had been inferred considering the algal biomass content, total protein, nucleic acids, and chlorophyll profiles of DK1 algal isolate as single-cell protein based food supplement. A comparative out rich had also been set forward to justify the industrial feasibility of newly isolated DK1 algal isolate with existing single-cell protein supplements, that is, mushrooms, existing algal single-cell protein candidates. The biomolecular profile had been showing that during the 18th day’s growth phase study of DK1 isolate, the residual amount of protein, chlorophyll, and nucleic acid (DNA, RNA) concentration (μg/mg) were first increased and after the 12th day, it was spontaneously decreased [Figure 8]. While the protein content of the well-known protein-rich algae A. platensis, Chlorella pyrenoidosa, and Aphanizomenon flosaquae is higher (62–65%), but in DK1 algal biomass, it is only 36%. However, the nucleic acid concentration of DK1 algal biomass, which is 0.52% of dry biomass, was lower than that of existing SCP algae regimes, that is, A. platensis. Once more, the protein levels of the DK1 algal isolate were shown to have higher and somewhat comparable [Table 1] to that of other mushrooms such as Agaricus bisporus (39%), Pleurotus sajor-caju (39%), and Volvariella volvacea (41.0%) [36-42]. This comparative overview on DK1 had been emphazing that DK1 algal isolate could have been considered as potent protein-rich food supplement, high nutritional value added biofactories [43]. Moreover, higher level of protein content with lower quantity of nucleic acids in DK1 algal isolate would be representing it as effective value added biomolecular platform toward food security and industrial sustainability [44,45]. Amelioration on SCP production using algal isolate DK1 could enforce DK1 algal isolate as future “Algal meat” or “Microbial meat” which can compete with animal and plant derived protein resources toward human consumption. Algal isolate DK1-based “Algal meat” may not only reduce the possibility of higher need for arable land usage but also minimize the potable water consumption in near future [46].
 | Figure 8: Biomolecular analysis on DK1 isolate (concentration [μg/mg] profile in dry biomass) (a) DK1 protein concentration profile; (b) DK1 chlorophyll concentration profile; (c) DK1 DNA concentration profile; and (d) DK1 RNA concentration profile. [Click here to view] |
9. CONCLUSION
The present study had clearly concluded that DK1 algal isolate seems most potent single-cell protein candidature out of all other algal isolates having higher protein, higher chlorophyll content with least quantity of total nucleic acids. According to these findings, the dry biomass of the organisms had a protein content of 36%, chlorophyll content of 13%, and nucleic acid content of 0.52% on the 12th day of the algal growth cycle. Hemolysin assay had clearly shown that DK1 algal isolate was non-pathogenic in nature and did not show any cellular toxicity. It was a good sign for human consumption considering usage of DK1 algal isolate. As future way forward, DK1 algal isolate had been needed for molecular identification and physicochemical parameter optimization in comparison to existing SCP-based algal assemblages for ameliorating total protein content, and biomass productivity toward commercialization it as algae-based single-cell protein supplement in near future.
10. ACKNOWLEDGMENT
The authors would like to thank JIS University, Kolkata, W.B, and JIS Group Educational initiatives. Authors also would like to thank Shrestha Debnath for her immense technical support during the progression of this research work.
11. AUTHORS’ CONTRIBUTION
Kamalendu De: All wet laboratory experimentation, data collection, data analysis, data set tabulation, data validation, investigation, wet laboratory experimental dataset visualization, original drafting, writing, and formatting. Dipankar Ghosh: Conceptualization, original drafting, writing, editing, reviewing, and supervision.
12. FUNDING
There is no funding to report.
13. CONFLICTS OF INTEREST
The authors declare that the authors have no conflicts of interest.
14. ETHICS STATEMENT
This article does not contain any studies with human participants or animals performed by any of the authors.
15. DATA AVAILABILITY
All datasets were obtained during this study and incorporated into the manuscript.
16. PUBLISHER’S NOTE
This journal remains neutral about jurisdictional claims in published institutional affiliation.
REFERENCES
1. Moi PS. Handbook of microalgal culture. Biotechnology and applied phycology. J Appl Phycol 2004;2:159-60. [CrossRef]
2. Nasseri AT, Rasoul-Ami S, Morowvat MH, Ghasemi Y. Single cell protein:Production and process. Am J Food Technol 2011;6:103-16. [CrossRef]
3. Ghosh D, Ghorai P, Debnath S, Indrama T, Kondi V, Tiwari ON. Algal biofertilizer towards green sustainable agriculture. In:Singh HB, Vaishnav A, editors. New and Future Developments in Microbial Biotechnology and Bioengineering. Amsterdam:Elsevier;2022 1:27-45. [CrossRef]
4. Wells ML, Potin P, Craigie JS, Raven JA, Merchant SS, Helliwell KE, et al. Algae as nutritional and functional food sources:Revisiting our understanding. J Appl Phycol 2017;29:949-82. [CrossRef]
5. Ciani M, Lippolis A, Fava F, Rodolfi L, Niccolai A, Tredici MR. Microbes:Food for the future. Foods 2021;10:971. [CrossRef]
6. Becker EW. Micro-algae as a source of protein. Biotechnol Adv 2007;25:207-10. [CrossRef]
7. Rajan DK, Mohan K, Zhang S, Ganesan AR. Dieckol:A brown algal phlorotannin with biological potential. Biomed Pharmacother 2021;142:111988. [CrossRef]
8. De K, Ghosh D. Microbial single cell protein generation:An existing comparative state of the art. In:De D, Roy S, Bera GC, editors. Biotechnology and Nature. Midnapore:Kabitika;2018. 94-98. Available from:https://www.researchgate.net/profile/Sovan-Roy-2/publication/330901248_biotechnology_and_nature/links/5d71f38aa6fdcc9961b20bbb/biotechnology-and-nature.pdf#page=92 [Last accessed on 2023 Jan 12].
9. Sadeghi S, Jalili H, Siadat SO, Sedighi M. Anticancer and antibacterial properties in peptide fractions from hydrolyzed Spirulina protein. J Agric Sci Technol 2018;20:673-83.
10. Ferruzzi MG, Blakeslee J. Digestion, absorption, and cancer preventative activity of dietary chlorophyll derivatives. Nutr Res 2007;27:1-12. [CrossRef]
11. Mishra VK, Bacheti RK, Husen A. Medicinal uses of chlorophyll:A critical overview. In:Le H, Salcedo E, editors. Chlorophyll:Structure, Function, and Medicinal Uses. Hauppauge:Nova Science Publishers;2011;177-96.
12. Cheirsilp B, Torpee S. Enhanced growth and lipid production of microalgae under mixotrophic culture condition:Effect of light intensity, glucose concentration and fed-batch cultivation. Bioresour Technol 2012;110:510-6. [CrossRef]
13. Pandian P, Ravindran D. Lipid extraction and CO2 mitigation by microalgae and its conversion into biodiesel. J Biochem Technol 2013;4:469-72.
14. Debnath S, Ghosh D. Mangrove algae as sustainable microbial cell factory for cellulosic biomass degradation and lipid production. J Appl Biol Biotechnol 2023;11:160-71. [CrossRef]
15. Griffiths MJ, Garcin C, van Hille RP, Harrison ST. Interference by pigment in the estimation of microalgal biomass concentration by optical density. J Microbiol Methods 2011;85:119-23. [CrossRef]
16. Slocombe SP, Ross M, Thomas N, McNeill S, Stanley MS. A rapid and general method for measurement of protein in micro-algal biomass. Bioresour Technol 2013;129:51-7. [CrossRef]
17. Bradford MM. A rapid and sensitive method for the quantitation of microgram quantities of protein utilizing the principle of protein-dye binding. Anal Biochem 1976;72:248-54. [CrossRef]
18. Oo YY, Su MC, Kyaw KT. Extraction and determination of chlorophyll content from microalgae. Int J Adv Res Publ 2017;1:298.
19. De K, Debnath S, Ghosh D. Elevating algal biomass generation toward sustainable utilization for high value added biomolecules generations. J Appl Biol Biotechnol 2022;11:16-27. [CrossRef]
20. Schagerl M, Künzl G. Chlorophyll a extraction from freshwater algae-a re-evaluation. Biologia 2007;62:270-5. [CrossRef]
21. Ismail MM, Osman ME. Seasonal fluctuation of photosynthetic pigments of most common red seaweeds species collected from Abu Qir, Alexandria, Egypt. Rev Biol Mar Oceanogr 2016;51:515-25. [CrossRef]
22. Debnath S, Ghosh D. Qualitative and quantitative studies on biopigment producing algal regime from marine water resources of Sundarban region. J Pure Appl Microbiol 2023;17:576-89. [CrossRef]
23. Chomczynski P, Mackey K, Drews R, Wilfinger W. DNAzol:A reagent for the rapid isolation of genomic DNA. Biotechniques 1997;22:550-3. [CrossRef]
24. Li X, Wu Y, Zhang L, Cao Y, Li Y, Li J, et al. Comparison of three common DNA concentration measurement methods. Anal Biochem 2014;451:18-24. [CrossRef]
25. Chomczynski P, Sacchi N. Single-step method of RNA isolation by acid guanidinium thiocyanate-phenol-chloroform extraction. Anal Biochem 1987;162:156-9. [CrossRef]
26. Almog R, Shirey TL. A modified orcinol test for the specific determination of RNA. Anal Biochem 1978;91:130-7. [CrossRef]
27. Huang B, Liang Y, Pan H, Xie L, Jiang T, Jiang T. Hemolytic and cytotoxic activity from cultures of Aureococcus anophagefferens-a causative species of brown tides in the north-western Bohai Sea, China. Chemosphere 2020;247:125819. [CrossRef]
28. Denaya S, Yulianti R, Pambudi A, Effendi Y. Novel microbial consortium formulation as plant growth promoting bacteria (PGPB) agent. IOP Conf Ser Earth Environ Sci 2021;637:012030. [CrossRef]
29. Sieracki ME, Benfield M, Hanson A, Davis C, Pilskaln CH, Checkley D, et al. Optical plankton imaging and analysis systems for ocean observation. Proc Ocean Obs 2010;9:21-25. [CrossRef]
30. John DM, Whitton BA, Brook AJ. The Freshwater Algal Flora of the British Isles:An Identification Guide to Freshwater and Terrestrial Algae. United Kingdom:Cambridge University Press;2002;14:702.
31. Krivina ES, Temraleeva AD. Identification problems and cryptic diversity of Chlorella-clade microalgae (Chlorophyta). Microbiol 2021;89:720-32. [CrossRef]
32. Irvani N, Carne A, Agyei D, Oey I. Algae as an alternative source of protein. In:Alternative Proteins. United States:CRC Press;2022;65-84. [CrossRef]
33. Ghosh D, Debnath S, De K. Impact of stress factors on plants for enhancing biomass generations towards biofuels. In:Plant Stress Biology. Canada:Apple Academic Press;2020. 313-28. [CrossRef]
34. El-Ashram S, Al Nasr I, Suo X. Nucleic acid protocols:Extraction and optimization. Biotechnol Rep (Amst) 2016;12:33-9. [CrossRef]
35. Yan Q, Dai Q, Liu B, Liu G, Zhu H. A new deep-water epilithic green alga, Ulvella lacustris, from an Alpine Brackish lake in Qinghai-Tibet plateau. Diversity 2022;14:594. [CrossRef]
36. Khannapho C, Phodee A, Paithoonrangsarid K, Hongsthong A, Meechai A, Cheevadhanarak S, et al. Effect of dilution rate in continuous cultures of Arthrospira (Spirulina) platensis C1 on nutrient use efficiency and macromolecular-and elemental compositions. J Appl Phycol 2021;33:743-54. [CrossRef]
37. Joha NS, Misran A, Mahmud TM, Abdullah S, Mohamad A. Physical quality, amino acid contents, and health risk assessment of straw mushroom (Volvariella volvacea) at different maturity stages. Int Food Res J 2021;28:181-8. [CrossRef]
38. Krishnamoorthi R, Srinivash M, Mahalingam PU, Malaikozhundan B. Dietary nutrients in edible mushroom, Agaricus bisporus and their radical scavenging, antibacterial, and antifungal effects. Process Biochem 2022;121:10-7. [CrossRef]
39. Triyono S, Haryanto A, Telaumbanua M, Lumbanraja J, To F, Cultivation of straw mushroom (Volvariella volvacea) on oil palm empty fruit bunch growth medium. Int J Recycl Org Waste Agric 2019;8:381-92. [CrossRef]
40. Mukhopadhyay R, Guha AK. Comprehensive analysis of the nutritional quality of edible mushroom Pleurotus sajor-caju grown in deproteinized whey medium. LWT Food Sci Technol 2015;61:339-45. [CrossRef]
41. Safafar H, NH, Nar H, PU, Ljubic A, MA, Mc P, Holdt SL, Jacobsen C. Enhancement of protein and pigment content in two Chlorella species cultivated on industrial process water. J Mar Sci Eng 2016;4:84. [CrossRef]
42. Niccolai A, Zittelli GC, Rodolfi L, Biondi N, Tredici MR. Microalgae of interest as food source:Biochemical composition and digestibility. Algal Res 2019;42:101617. [CrossRef]
43. Mishra PK, Chatterjee S, Gautam RK, Kakatkar AS, Kumar V. Marine algal carbohydrate and peptide antioxidants. In:Marine Antioxidants Preparations, Syntheses, and Applications. United States:Academic Press;2023;473-88. [CrossRef]
44. Barbosa MJ, Janssen M, Südfeld C, D'Adamo S, Wijffels RH. Hypes, hopes, and the way forward for microalgal biotechnology. Trends Biotechnol 2023;41:452-71. [CrossRef]
45. Nguyen NH, Nguyen QT, Dang DH, Emery RJ. Phytohormones enhance heavy metal responses in Euglena gracilis:Evidence from uptake of Ni, Pb and Cd and linkages to hormonomic and metabolomic dynamics. Environ Pollut 2023;320:121094. [CrossRef]
46. Alves SC, Díaz-Ruiz E, Lisboa B, Sharma M, Mussatto SI, Thakur VK, et al. Microbial meat:A sustainable vegan protein source produced from agri-waste to feed the world. Food Res Int 2023;166:112596. [CrossRef]
Supplementary Figures
 | Supplementary Figure 1: Calibration curve of collected algal isolates in (mg/mL) on dry biomass. [Click here to view] |
 | Supplementary Figure 2: (a) Protein standard curve; (b) DNA standard curve; and (c) RNA standard curve. [Click here to view] |